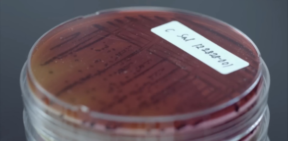

Вернуть отравителю. Документалка «Грязная правда о вашей еде» — в пяти абзацах
Вернуть отравителю. Документалка «Грязная правда о вашей еде» — в пяти абзацах
ЛАЙФСТАЙЛ | БИБЛИОТЕКА
ВРЕМЯ ЧТЕНИЯ: 8 МИНУТ
12/08/2023
Текст: Алексей Исаков
Фото: Netflix
Netflix ушел из России больше года назад, но оставил нам в наследство много привычек, например вернуться домой с работы и задумчиво поужинать под увлекательную документалку в жанре тру-крайм. Недавний хит платформы — документальный фильм «Отравленные: грязная правда о вашей еде» — тоже история о преступлении, наказании и многочисленных жертвах. Но прежде всего об опасностях, которые всегда рядом. Алексей Исаков посмотрел полуторачасовой фильм об ужасах пищевой промышленности, но аппетита не потерял.
Сперва может показаться, что фильм имеет к нам с вами мало отношения, ведь он о еде американской, то есть выращенной, приготовленной или хотя бы съеденной в Соединенных Штатах Америки. Но на самом деле здесь поднимут проблемы, вполне понятные гражданину любой страны, пережившей превращение сельского хозяйства в агропромышленность. Да что уж там — понятные вообще всем. В этой американской истории отравлений злодеи либо столь малы, что не разглядеть без микроскопа, либо столь велики, что сверху вниз смотрят и на сенат, и на конгресс, и уж тем более на беспомощные контролирующие органы. Жертвы хорошо различимы, поскольку соразмерны нам, зрителям. Не доживший до своего первого урока дошколенок, не успевший насладиться заслуженным отдыхом военный пенсионер, старшеклассница, которой «повезло» больше прочих — она просто нуждается в диализе. Все они просто «что-то не то» съели: непрожаренный бургер с кишечной палочкой, зараженный листовой салат, арахисовую пасту с возбудителем сальмонеллеза.
Авторы фильма, а вместе с ними и большинство спикеров: активисты, общественники, ученые и родственники жертв — задаются вопросом, как же так вышло, и это не безответный вопль в небеса — с переменным успехом на него отвечают пара представителей крупного бизнеса и пара государственных чиновников в ранге замминистра. И те и другие чувствуют себя крайне неловко, говорят обтекаемо и очевидно жалеют, что согласились на интервью. Чуть бодрее держится перед камерой бывшая замминистра сельского хозяйства Минди Браширс, но ей, как и большинству назначенцев президента Трампа, терять уже нечего. Общий рефрен довольно однообразен: мы делаем все, что можем, не все в нашей власти, нам кажется, мы достигли значительных успехов. Для каждого из ответственных лиц у журналистов найдется вопрос с подвохом: о грантах на исследования, похожих на взятки, о сальмонеллезе у каждой шестой курицы, выращенной агрогигантом Purdue, наконец, о том, почему контролеры из минсельхоза до сих пор считают эффективной мерой контроля визуальный осмотр каждой куриной тушки на птицефабрике. Впрочем, на этот последний вопрос нынешняя замминистра сельского хозяйства Сандра Эскин отвечает уверенно: «Мы считаем, что это необходимая мера, потому что этого требует закон». Тут подошла бы веселая музыка из немого кино, ведь осматривать кур визуально, чтобы выявить больных, требует закон, принятый еще при президенте Теодоре Рузвельте, то есть примерно во времена Русско-японской войны. Кстати, по словам одной из таких контролеров (женщина пожелала остаться анонимной), ей приходится осматривать
134 куриные тушки в минуту.
Комедия административного абсурда в этом документальном фильме постоянно сменяется гастрономическим хоррором, поскольку быстро оказывается, что употреблять в пищу в агропромышленном мире опасно буквально все — от дынь до куриного фарша. И в этой тревожной части удивительным образом сосредоточена главная слабость «Отравленных». Душераздирающие истории погибших и выживших, пугающую статистику про миллионы пищевых отравлений и тысячи ежегодных смертей режиссер Штефани Зохтиг использует, чтобы вызвать у зрителей волну праведного гнева, но попутно топит их в осознании беспомощности перед силами природы и олигополиями. К слову, здесь не обходится без умолчаний: эпидемии кишечной палочки, представленные как сугубо американское явление, не чужды и куда более зарегулированной Европе. Так, вспышка 2011 года в Германии, унесшая жизни полусотни человек, началась со сравнительно небольшой «органической фермы», купившей в Египте зараженные семена. Но возможно, Старый Свет Штефани Зохтиг не интересует, так что на протяжении всего фильма нам вполне достоверно и убедительно рассказывают, как американский крупный бизнес десятилетиями пытался переложить на потребителей все риски, связанные с испорченными продуктами, но в качестве рецепта предлагают просто развернуть ситуацию на 180 градусов и уже самим снять с себя всю ответственность за собственные жизнь и здоровье.
Формула довольно простая: одна бактерия сальмонеллы заразит всю вашу кухню, нет гарантий, что вы сможете смыть с листьев шпината всю кишечную палочку, дыня канталупа — самый опасный продукт #прямосейчас, потому что не получится разрезать дыню, не занеся инфекцию под кожуру. А раз так, но можно и не пытаться себя обезопасить. Не нужно тщательно мыть овощи и зелень, менять ножи при готовке, мыть руки, в конце концов. Лучше просто обходить за километр мясника и прилавок с овощами, так же как протагонисты этого фильма отважно отказались от стейков с кровью, устриц, куриного филе и даже салата ромен. Тем, кто на такой подвиг все еще не готов, остаются рекомендации Американского центра по контролю за заболеваниями: вымойте заранее руки, мойте овощи и зелень под сильным напором проточной воды, заранее избавьтесь от всех надорванных и поврежденных листьев, с капусты и кочана салата сорвите верхние листы, оботрите вымытую зелень и овощи чистой тканью или бумажным полотенцем. Тут стоит отметить, что исследование шведских ученых, на первый взгляд, подтверждает правоту авторов фильма. «Мытье зелени в домашних условиях не дает нужного эффекта, удаляя лишь от 68 до 80 процентов бактерий», — объясняют шведы, но дальше сами же оговариваются, что нужного результата удается добиться лишь при напоре от 8 литров в минуту. И кажется, при российских тарифах на водоснабжение мы все еще можем позволить себе такую роскошь. А дальше, как сказал самый смелый микробиолог в фильме, — «Я знаю, что рискую, когда ем салат».
Раскрываем силу еды вместе